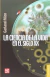
La ciencia de la vida en el siglo XX (342)

Descripción
Garland Edward Allen
LA CIENCIA DE LA VIDA EN EL SIGLO XX (342)
FONDO DE CULTURA ECONOMICA FCE
Páginas: 523
Formato: 17 x 11 cm
Peso: 0.3 kgs.
ISBN: 978-607165673-5
Encuadernación: TAPA SUAVE
Año de edición: 1983
Colección: BREVIARIOS
El legado darwiniano otorgó a las ciencias de la vida una fecunda riqueza metodológica, base de los avances que en nuestro siglo han producido una revolución que ha hecho florecer la bioquímica, la biología molecular, la embriología y la moderna fisiología. Este libro está dedicado al profesor, al estudiante y al lector interesado en estas cuestiones.